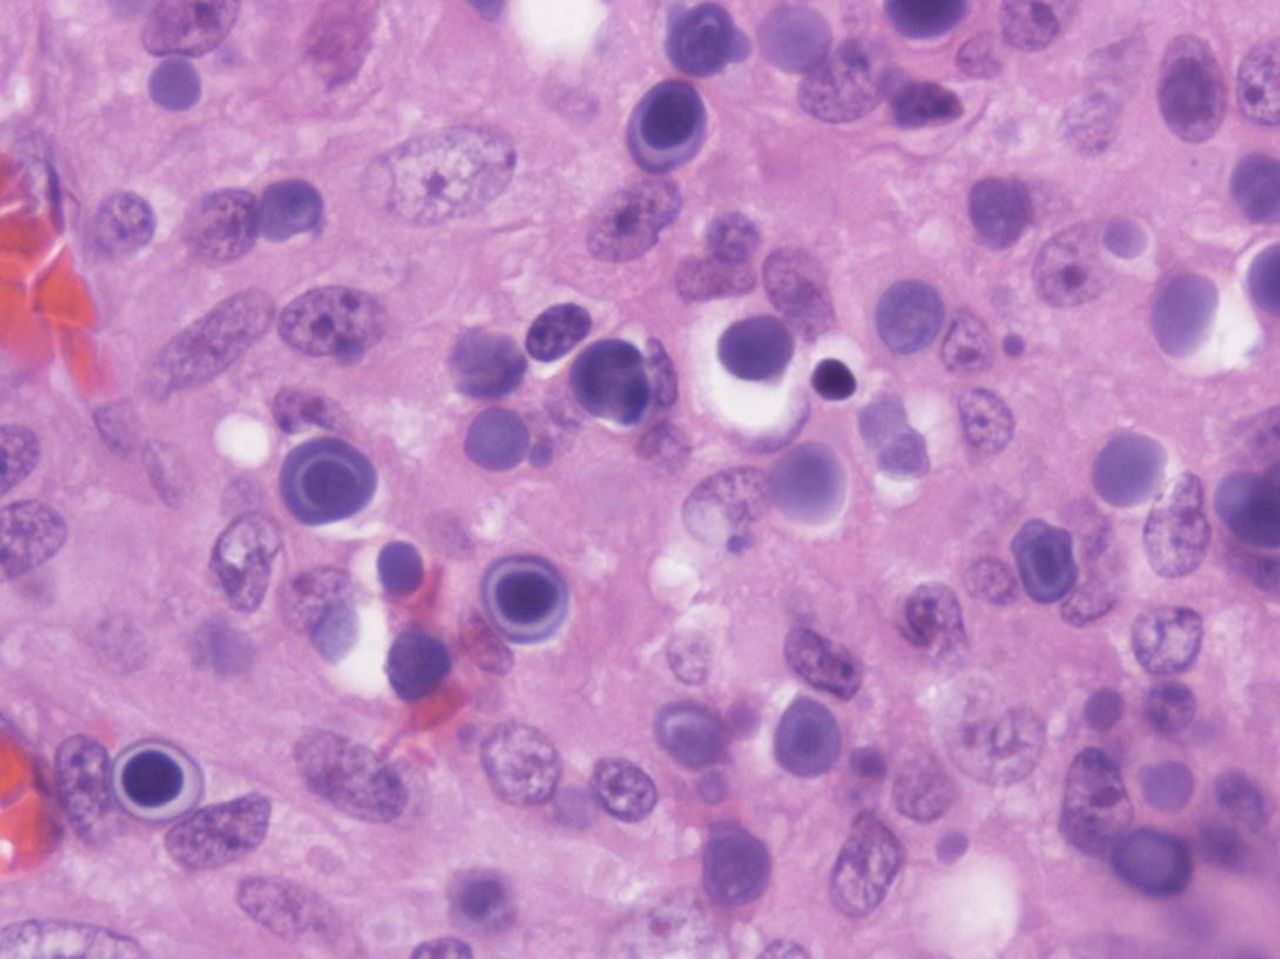
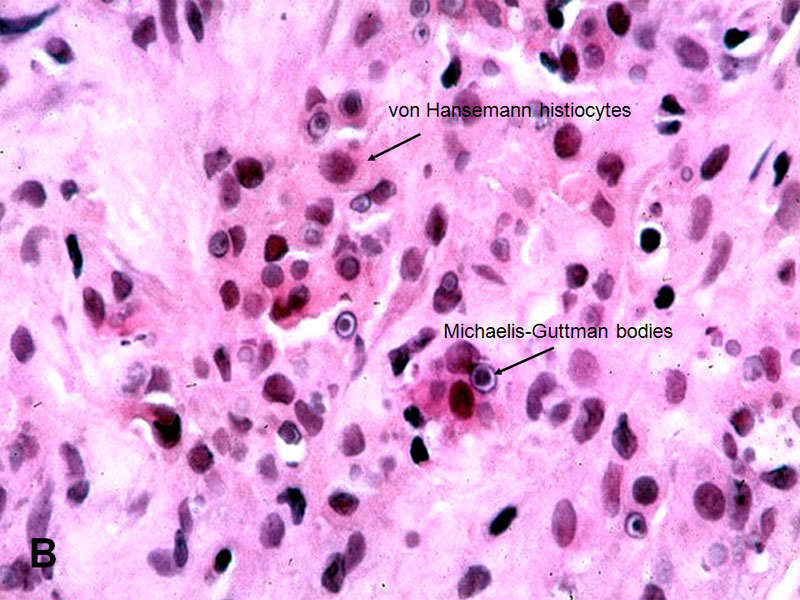
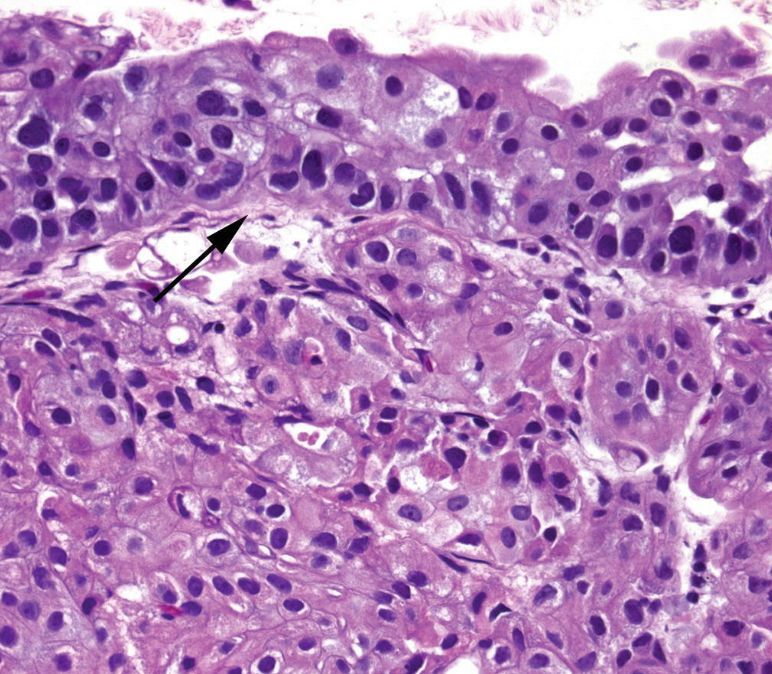

Normal urothelium
5-7 cells thick with umbrella cells at the top
Unlike squamous epithelia, these cells do not significantly mature as they reach the surface. Nuclei are 2-3x the size of lymphocytes and oriented perpendicularly to the epithelium.
The muscularis propria of the bladder. . .
. . . is the detrusor muscle

von Brunn’s nests
Invaginations of the normal urothelium into the lamina propria.
The center often acquires a lumen and columnar cell metaplasia (rather than umbrella cells). This variant is called cystitis glandularis (shown here).
Very common.

Granulomatous cystitis
In theory could be caused by TB, or even schistosoma, but nowadays is mostly seen secondary to BCG chemotherapy for urothelial carcinoma (intracystic injection of the BCG vaccine).

Schistosomiasis
Note the visible eggs, which appear as dark purple ovals with single spines. Appears in a background of granulomatous cystitis.
Eggs may be calcified (as seen on the front) or not (as seen below). When uncalcified, they look almost like a large clump of giant cells.

Malakoplakia
Yellow plaques seen on cystoscopy.
Formed by sheets of epithelioid histiocytes (called van Hansemann histiocytes) sporting characteristic round inclusions called “Michaelis-Gutmann bodies”. They look like archery targets.
Caued by defective macrophage response to infection, usually E. coli.
Two cancer pathways of urothelial neoplasms
Flat: Does not form exophytic lesions, but is visible as a red patch on the bladder. Progresses through dysplasia to carcinoma in-situ. In urology, “carcinoma in-situ” refers specifically to flat CIS, even though papillary lesions can also be “CIS”.
Papillary: Has a wide spectrum of disease, from benign to high-grade carcinoma. Papillary lesions are conventionally called noninvasive papillary urothelial carcinoma rather than carcinoma in-situ, even though that is what they are.
Both can lead to invasive carcinoma.

Flat urothelial carcinoma in-situ
The urothelium is partially denuded, but the cells that remain show enlarged, round, hyperchromatic nuclei that appear to “pop off” of the surface. Some look like balloons about to float away. The nuclear size is ~4-5x that of a lymphocyte.
Full thickness involvement is NOT a requirement to diagnose CIS.

Urothelial papilloma
Note that the urothelium resembles normal urotheium both in thickness and in cytology. Some large umbrella cells are visible.
Sometimes the normal urothelium can look wavy or tufty, so make sure that there is a true fibrovascular core before calling a papilloma.

Papillary urothelial neoplasm of low malignant potential (PUNLMP)
A category for proliferative neoplasms that are larger and “fuller” than a papilloma, but do not appear to be malignant. Urothelial lining and thickness are well organized, with nuclei streaming in parallel. Mitoses should be exceedingly rare and confined to the basal layer.
Their behavior is intermediate between a papilloma and low-grade papillary carcinoma.


Low-grade papillary urothelial carcinoma
Thin fibrovascular cores lined by a urothelium that is thicker than normal. Still fairly well organized (most cells polarized with respect to surface). There is scattered, subtle nuclear atypia consisting of random slightly enlarged, darker nuclei, in contrast to PUNLMP (where every nucleus looks the same). Mitoses are uncommon, but should be present.

High grade papillary urothelial carcinoma
Papillary lesion lined by cells that look like CIS. May be noninvasive, but you have to look carefully for associated invasion (because it is often present!)
The urothelium is disordered with poor polarization. Nuclei are enlarged, hyperchromatic, and pleomorphic, maybe with nucleoli. Mitoses are seen at all levels of the epithelium and there is focal non-urothelial differentiation (squamous or glandular).
Invasive urothelial carcinoma, or “the tumor formerly known as ‘transitional cell carcinoma’”
Most arise within the setting of either high-grade papillary urothelial carcinoma or flat carcinoma in-situ.
Characterized by irregular tongues of cells or single cells pushing into the lamina propria. “Paradoxical differentiaton” is often present. A retraction artifact separating the stroma from tumor nests is present in H&E preparations. There may or may not be a desmoplastic response.
Paradoxical differentiation
Seen in invasive urothelial carcinoma/transitional cell carcinoma
The deep invasive cells acquire increased pink cytoplasm, mimicking mature surface cells.
Identifying ___ is critically important in invasive urothelial carcinoma.
Identifying the muscularis propria/detrusor muscle is critically important in invasive urothelial carcinoma.
Superficial tumors that do not invade the muscularis propria are treated conservatively by transurethral resection or topical chemotherapy/brachytherapy.
Invasion of the muscularis propria buys the patient a cystectomy.

Inverted papilloma
Common mimicker of carcinoma. When the papilloma grows down.
The tumor appears buried in the stroma, but does not really cross the basement membrane. Cells are also generally benign and well-differentiated.

Nephrogenic adenoma
A benign proliferative neoplasm that can take on many appearances (cuboidal cells lining papillary fronds, hobnail cells lining vessel-like structures, small infiltrative-looking tubules, thyroid-like accumulations of colloid – even signet ring-like morphology).
In all cases, these differ from urothelial lesions by being single-layered epithelium and more cuboidal. There may be focal large, dark nuclei, but uniform dense chromatin and no mitoses.
Metastatic prostate adenocarcinoma is on the differential and must be excluded.

Lymphoepithelial-like carcinoma
Gives off an overall impression of raging inflammation and tissue destruction. Sheets of lymphocytes are present. But, the actual carcinomatous cells tend to fade into the background.
The nuclei are large and bubbly and not particularly hyperchromatic or carcinoma-like. The cytoplasmic borders are indistinct, almost syncytial. Atypical mitoses may be present.
A cytokeratin stain is helpful.

Urothelial carcinoma-in-situ.
Increased thickness with anisonucleosis and hyperchromasia, often overlying a lymphocytic stroma with occasional intraepithelial lymphocytes. Loss of maturation of basal cells.
By definition, you can only say this if there are no lesions of invasion into the stroma.
Types of primary bladder cancer


**Primary squamous cell carcinoma of the bladder
**
1.5-2.5% of bladder cancers in the US, but >50% of bladder cancers in schistosomiasis-endemic regions (~75% of cases in Egypt).
Histology: Squamoid features, sometimes with keratinization and often with intercellular bridging. Since schistosoma is associated, schistosoma eggs may be present and you should look for these if you are suspecting SCC of the bladder. Also reviewing travel history wouldn’t hurt.
Often presents with advanced stage, >95% muscle-invading by presentation. 20% LN involvement, but low rate of distal metastasis. 90% of associated deaths are due to local recurrence.
Do not respond well to chemo - early cystectomy is advised.

**Urachal adenocarcinoma ** .
Arise from the urachal remnant (embryologic belly button-bladder connection). Hence, they are usually found in the bladder dome or in the midline.
Accounts for 1/3 of primary bladder adenocarcinomas. Tend to be in younger patients. Mostly (~65%) low grade.
May have a glandular, colloid, papillary, signet ring, or clear cell morphology. 90% are mucus producing.
Stains: Diffuse 34 beta E12 positivity, CK20+, CDX2+, CK7+, CEA+, nuclear beta-catenin negative.
Genetics: KRAS, NRAS, or BRAF – similar to colonic adenocarcinoma

** Non-urachal adenocarcinoma of the bladder **
Accounts for 2/3 of primary bladder adenocarcinomas.
Most often displays intestinal-type architecture and cytology. Often high-grade at presentation. Intestinal-type metaplasia is a predisposing factor.
Rule-out of a primary gastrointestinal cancer is part of the standard work-up (endoscopy, colonoscopy).
Stains: Diffuse nuclear beta-catenin positive, 34 beta E12 negative
UroVysion
A type of FISH test for bladder cancer that can be used on urine cytology or washing specimens.
Utilizes centromeric probes for chromosomes 3, 7, and 17, as well as a locus-specific probe for 9p21.
Evaluation of 25 morphologically abnormal cells is more sensitive than evaluation of 100 random cells.
CIS is more likely to be FISH positive than papillary urothelial carcinoma (since CIS is more of a precursor to HGUC than to PUC).


